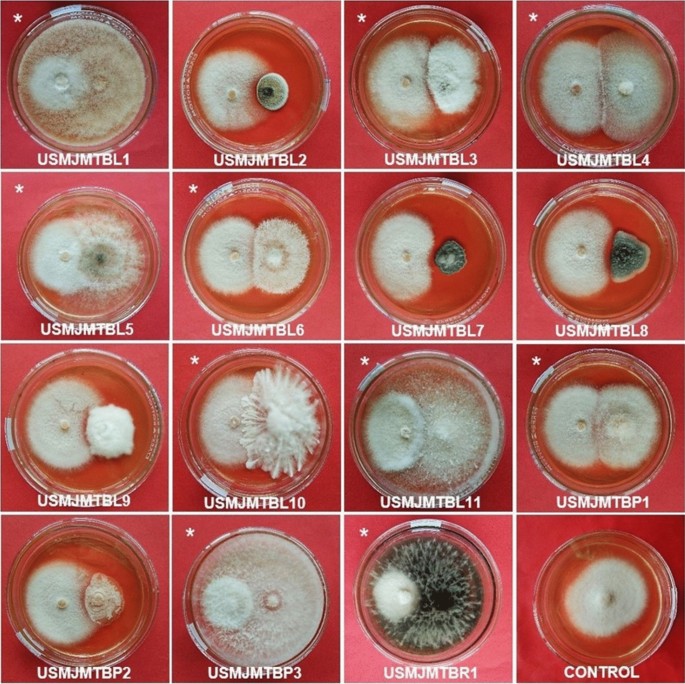

- Research
- Open access
- Published:
Fungal endophytes as potential biocontrol agent of Panama disease of banana
Egyptian Journal of Biological Pest Control volume 33, Article number: 84 (2023)
Abstract
Background
Fusarium odoratissimum (Foc TR4) is a devastating fungal pathogen that causes Panama wilt in Cavendish banana, a high value crop that generates significant revenue. The excessive use of synthetic fungicides for disease control poses risks to both human health and the environment. Consequently, there is a pressing need for eco-friendly alternatives to manage this disease. One potential approach is the utilization of biocontrol agents, which have shown promise in disease control. This study aimed to evaluate the biocontrol potential of fungal endophytes isolated from the naturally-resistant cultivar Cardaba banana against Foc TR4. These fungal isolates were subjected to a dual culture assay, characterized based on morpho-cultural characteristics, and confirmed molecularly using the internal transcribed spacer (ITS) region of rDNA.
Results
Of the 15 fungal endophytes isolated from Cardaba; Blakeslea trispora, Pseudopestalotiopsis theae, Xylaria badia, Nigrospora hainanensis, Colletotrichum gloeosporioides, Xylaria feejeensis, Gymnoascus reessii, Fusarium subglutinans, Rigidoporus vinctus, and Macrophomina phaseolina showed potential antagonistic activity against F. odoratissimum. Isolates X. feejeensis (USMJMTBL10), G. reesii (USMJMTBL11), and M. phaseolina (USMJMTBR1) had the highest antagonistic activity of 87.8–96.6% against F. odoratissimum in vitro.
Conclusion
This study presents evidence of the potential of Cardaba-associated endophytes isolated and identified in this research, as effective biocontrol agents against F. odoratissimum, the causal agent of Panama disease in Cavendish banana. Our findings suggest that these endophytes hold promise as a biocontrol agent for managing Foc TR4-infected banana plants. Future research will focus on in planta testing, validation in greenhouse and field trials, as well as development of formulations and application protocols to optimize the utilization of these biocontrol agents in an integrated management approach for Foc TR4-infected bananas.
Background
Banana (Musa spp.) continues to dominate the global fruit market, with over 135 countries involve in its production (FAO 2021). Over the years, its production and cultivated areas have increased (FAO 2021). Aside from being a major cash crop, bananas are grown in tropical and subtropical regions for local consumption (Olaoye and Ade-Omowaye 2011). In 2020, banana exports reached an estimated 22.2 million tons, with 1.7% increase compared to 2019. This growth was primarily attributed to the successful implementation of disease mitigation strategies in banana plantations of the top exporting countries, namely Ecuador, Costa Rica, and Colombia (FAO 2021). In Asia, 90% of exported bananas originate in the Philippines (Department of Agriculture 2019). However, the country experienced a significant decline of 46% in banana exports due to a decrease in production caused by Panama wilt, attributed to F. odoratissimum (Thangavelu et al. 2019).
Banana cultivars are highly susceptible to diseases (Molina et al. 2008). While the Cavendish banana, a triploid (AAA) cultivar of Musa acuminata, exhibits resistance to Fusarium oxysporum f. sp. cubense (Foc) race 1 (R1), which destroyed ‘Gros Michel’ cultivar, it remains susceptible to Foc tropical race 4 (TR4), now known as F. odoratissimum (Thangavelu et al. 2019). Foc TR4 is a virulent strain of Foc that poses a severe threat to the global Cavendish banana industry. In the Philippines, the presence of Foc TR4 was first confirmed in 2005, affecting numerous Cavendish farms in the Mindanao provinces of the Southern Philippines (Molina et al. 2008).
Chemical soil fumigation and the use of resistant cultivars are the two methods commonly employed for managing Panama wilt (Fravel et al. 2003). Broad-spectrum biocides such as methyl bromide have been used for soil fumigation before planting. However, these are harmful to human health and detrimental to the environment. Alternatively, genetic resistance provides a sustainable long-term approach for managing and controlling Panama wilt. The use of resistant cultivars is cost-effective and environment-friendly technique for pathogen control (Fravel et al. 2003). Yet, there are currently no commercially viable cultivars available that exhibit resistance against Foc TR4 (Chen et al. 2019).
Considerable efforts have been done to search for resistant cultivars against Foc TR4 (Zuo et al. 2018). However, transferring the favourable alleles from the resistant cultivar into a commercially viable cultivar with good agronomic traits is challenging (Dita et al. 2018). Resistant traits to Foc have been identified in wild banana species (Li et al. 2014) such as in Musa acuminata ssp. Malaccensis, which exhibits resistance to Foc race 1 (Ahmad et al. 2020). Notably, the Cardaba cultivar (Saba subgroup) in the Philippines showed an absence of Foc TR4 infection (Molina et al. 2016), indicating its resistance to Panama disease. Additionally, Solpot et al. (2016) found that Cardaba cultivar of banana, a triple hybrid that originated from the Philippines, remains free from Foc TR4 infection in South-Central Mindanao.
Another influential factor contributing to the resistance of certain cultivars is the diverse microbial community associated with the banana plant (Catambacan and Cumagun 2021). Several studies have demonstrated that the synergistic and cumulative effects of microbial communities enhance a plant's resistance to biotic and abiotic challenges while promoting growth. Specifically, the application of microbial antagonists and/or organic fertilizers has shown promising results in altering the microbiota of the banana rhizosphere, leading to effective control against Foc TR4 (Xue et al. 2015).
The challenge of effectively controlling Panama wilt has prompted research in biological control to manage soil-borne pathogens (Khan et al. 2018). Fungi possess several characteristics as candidates for biological control agents, as they help control pathogenic organisms that attack plants. For instance, fungi can inhibit or reduce the infection of the pathogen in host plants or impede the initial establishment of the pathogen (Thambugala et al. 2020). Additionally, fungi can also colonize tissues of plants as endophytes (Arnold 2007). Endophytic fungi not only contribute to reducing disease severity but also promote plant growth, induce plant defense mechanisms, and produce compounds with anti-herbivore properties (Rudgers et al. 2007). Therefore, the aim of this study was to isolate fungal endophytes from the naturally-resistant Cardaba variety and evaluate their potential as a biocontrol agent against F. odoratissimum (Foc TR4) causing Panama wilt in Cavendish banana.
Methods
Culturing and molecular analysis of F. odoratissimum
The Foc isolate was obtained from the Plant Pathology Research Laboratory, University of Southern Mindanao Agricultural Research and Development Center, USM, Kabacan, Cotabato, Philippines. The isolate was subcultured in PDA (Potato Dextrose Agar) medium supplemented with ampicillin and incubated for 14 days. Figure 1A and B show the F. odoratissimum isolate at 14 days of incubation in PDA medium. The colony growth of F. odoratissimum isolate exhibited a white cottony and/or fluffy aerial mycelium, which corresponds to the description of Leslie and Summerell (2006) on Foc mycelia in PDA. Figure 1C shows the chlamydospores in pairs at 3 weeks of incubation, and in single and/or in chains at 2 months of incubation (Fig. 1D). The macroconidia are falcate to upright to practically straight and the microconidia appeared oval to kidney-shaped (Fig. 1E) typical for the description of F. odoratissimum isolate (Perez-Vicente et al. 2014).
Cultural and morphological characteristics of Fusarium odoratissimum grown in PDA plate. A Obverse view. B Reverse view. C Chlamydospores under the microscope appear in pair (see arrow). D Chlamydospores (single and/or in chains). E Oval to kidney-shaped microconidia (in arrow) and falcate to upright to practically straight macroconidia (in asterisk)
To validate the isolate as Foc TR4, genomic DNA of Foc isolate was extracted following the DNEasy Powersoil kit protocol. The extracted DNA was quantified using a spectrophotometer (MultiSkan Sky, ThermoFisher). The PCR amplification was carried out through Promega Go Taq 2 × MasterMix using universal primers F-ITS1 (5′-TCCGTAGGTGAACCTGCGG-3′) and F-ITS4 (5′-TCCTCCGCTTATTGATATGC-3′) by White et al. (1990). The following conditions were followed: initial denaturation at 94 °C for 2 min, followed by 35 cycles of each denaturation at 94 °C for 30 s, primer annealing at 57 °C for 30 s, extension at 72 °C for 2 min, and at last 1 cycle final extension at 72 °C for 10 min. The PCR product was purified following the protocol of Vivantis Gel/PCR Purification kit. Sequencing was done using Genetic Analyzer SeqStudio (Thermo Fisher) kit: Big Dye Terminator kit V3 (Philippine Genome Center). The forward and reverse sequences were trimmed, aligned, and cleaned up using FinchTV, BioEdit, and Molecular Evolutionary Genetics Analysis (MEGA). The generated DNA sequence of the Foc TR4 isolate used in this study was analysed using the Basic Local Alignment Search Tool (BLAST) of the National Center for Biotechnology Information (NCBI), where functional and evolutionary relationships between the DNA sequences can identify members of gene families (https://blast.ncbi.nlm.nih.gov/Blast.cgi). The DNA sequence homology from the BLASTn search revealed that the Foc isolate used in this study had a significant BLAST hit with the fungal organism belonging to F. oxysporum f. sp. cubense, which corresponds to the deposited Foc TR4 sequence in NCBI GenBank (Nakkeeran et al. 2021).
Pathogenicity test of F. odoratissimum isolate
The pathogenicity test was conducted following the technique of Catambacan and Cumagun (2021) with some modifications. Six tissue-cultured Cavendish cv. Grand Naine banana plants, aged four weeks, were transplanted into 350 cm3 pots filled with sterile clay loam. Prior to inoculation, two root hairs of each plantlet were exposed and wounded using a sterile scalpel. A two-week-old pure culture of Foc TR4 was then inoculated to the base of the three plantlets by drenching 50 ml spore suspension (106 spores per ml). The inoculated roots were immediately covered with soil. Another three plantlets were designated as the uninoculated control treatment and were applied only with sterile PDA media. At two and four weeks post-inoculation, the banana plantlets were assessed for the presence of typical symptoms associated with Panama wilt. Yellowing of old leaves (Fig. 2A) and vascular discoloration (Fig. 2B) were observed two weeks after inoculation. The symptoms of Foc TR4 infection in this study correspond to the study of Catambacan and Cumagun (2021). The uninoculated plantlets were all healthy with no visible yellowing of leaves nor pseudostem discoloration (Fig. 2C, D). After the pathogenicity testing, the materials and the soil were heat-sterilized, and the infected banana plantlets were properly disposed by burning.
Isolation and culturing of the fungal endophytes
Healthy leaves, pseudostem, and roots were randomly collected from five young (≤ 6-months) and five old (> 6-month-old) Cardaba banana which were not sprayed with chemicals from a backyard banana farm at Hagonoy, Davao del Sur, Philippines for the isolation of fungal endophytes. The leaves were obtained by directly cutting a section of the lamina near the petiole, extending to the edge of the midrib. The pseudostems were collected by cutting a triangular shape with a depth of 3 inches from the outer to the inner portion of the pseudostem, while the roots near the corm were collected. Subsequently, the samples were placed inside the sterile plastic bags and processed in the laboratory to isolate the fungal endophytes. Three replications of each plant part were considered for a total of 90 plant samples.
Endophytes were isolated immediately after sampling following the standard procedure described by Pujade-Renaud et al. (2019). Banana leaves and pseudostems were divided into three segments, each measuring about 3 × 3 mm. These segments were briefly immersed in solutions consisting of 2% (vol/vol) sodium hypochlorite solution, 70% (vol/vol) ethanol, and sterilized water. Afterwards, they were planted equidistantly on flat bottles containing Malt Extract Agar (MEA). For root samples, 5 g of fresh root sample was soaked in a 100 ml solution containing 5% sodium hypochlorite and agitated for 5 min. Subsequently, the roots were immersed in 70% ethanol for 10 min to ensure complete surface sterilization. The root surface was thoroughly rinsed three times with sterilized water to remove any residual sterilizing agents. The surface-sterilized roots were cut into 1 cm sections and was placed equidistantly on flat bottles with MEA supplemented with ampicillin (Catambacan and Cumagun 2021). These were incubated for 3–7 days at 28 °C. Subsequent transfer to PDA medium was performed to purify the fungal endophytes. In this study, a sterile PDA medium served as the negative control.
Dual culture test
Pure cultures of fungal endophytes were subjected to a dual culture method (Rahman et al. 2009) to assess the interaction and antagonism between the isolated fungal endophytes and the pathogen Foc TR4 within the same Petri plate. Five mm diameter of mycelial plugs from a 7-day-old Foc TR4 culture and fungal antagonist were obtained using a sterile cork borer. The mycelial plug was placed two cm from the edge of the plate, while the pathogen was positioned at the opposite side of the antagonist. The setup for the dual culture assay was replicated three times. A PDA plate inoculated solely with the pathogen served as the control. The plates were then incubated at 28 °C for a period of 7 days.
The fungi were evaluated using the rating scale developed by Bell et al. (1982) with stages 1–5 representing the overgrowing capabilities of the fungal endophytes, where Stage 1 = the antagonist completely outgrew the pathogen and took up the entire surface of the medium, Stage 2 = the antagonist outgrew the pathogen by at least two-thirds, Stage 3 = the antagonist and the pathogen each colonized half of the medium surface, Stage 4 = the pathogen outgrew the antagonist by at least two-thirds, and Stage 5 = the pathogen completely outgrew the antagonist and took up the entire surface of the medium. If the mean score, rounded to the closest whole stage, for a specific comparison was less than or equal to two, a fungal endophyte (FE) was considered antagonistic to the pathogen.
Percentage inhibition of pathogen was calculated by the following formula (Fokkema 1973):
where R1 = the radial growth of Foc TR4 in the control plate (mm), and R2 = the radial growth of Foc TR4 towards the antagonistic fungi (mm).
The fungal endophytes’ antagonistic activity was described using the technique of Soytong (1988) where > 75% means very high antagonistic activity, 61–75% as high antagonistic activity, 51–60% being moderate antagonistic activity, and > 50% as having low antagonistic activity.
Morpho-cultural characterization of the fungal endophytes
The stock cultures of the purified fungal endophyte isolates were grown in PDA plates and incubated at room temperature in an inverted position. Fungal growth was observed daily for a duration of 7 days, then growth diameter was measured and various colony morphology parameters such as shape, texture, surface, and reverse color were recorded. For microscopic examination, the scotch tape method was used wherein a piece of scotch tape was placed on the top of each fungal endophyte isolate. One drop of lactophenol cotton blue was added to the slide and the tape with fungal endophytes was positioned on top. The slide was examined under a 100–1000 × light microscope. Identification of fungal endophytes was based on their morphological characteristics, primarily at the genus level (Barnett and Hunter 1998). Endophytic fungal isolates which did not produce any spores in culture media were categorized as non-sporulating fungal endophytes.
Molecular identification of the fungal endophytes
DNA extraction
Fungal endophytes belonging to stages 1–3 of Bell’s rating and exhibiting moderate to very high inhibitory activity against Foc TR4, as determined by the dual culture assay were further identified using molecular analysis. The 7 days old fungal isolates grown in PDA at 28 °C were carefully scraped using a scalpel to isolate fungal DNA. Genomic DNA was extracted using the Norgen Biotek Corp plant/fungi DNA isolation kit, following the manufacturer’s protocol. The concentration and purity of DNA samples were assessed and quantified using the SPECTROstar Nano instrument.
PCR amplification
Amplification of the internal transcribed spacer (ITS) region of the fungal isolates was performed using the universal forward primer ITS-1 (5′-TCCGTAGGTGAACCTGCGG-3′) and reverse primer ITS-4 (5′-TCCTCCGCTTATTGATATGC-3′) as described by White et al. (1990) with a target size of 550–700 bp of the amplicon. PCR amplification was carried out on a programmable Veriti 96 Well Thermal Cycler in 0.2 mL PCR tubes containing 5 µl of DNA template, 25.5 µl ddH2O, 14 µl 5 × MyTaq reaction buffer, 1.5 µl of Taq, and 2 µl of each primer, a total volume of 50 µl PCR reaction. Conditions that were used for PCR amplification included initial denaturation at 95 °C for 1 min followed by 35 cycles of each denaturation at 95 °C for 15 s, primer annealing at 52 °C, 54 °C, 56 °C, and 58 °C (via VeriFlex) for 15 s, and an extension at 72 °C for 10 s. A non-template negative control was included in each PCR run to monitor for potential contamination.
Gel electrophoresis and visualization
The integrity and quality of PCR products were assessed using Labnet's ENDURO™ Gel XL Electrophoresis System. A volume of 4 µl of each PCR product was loaded onto a 0.8% agarose gel supplemented with 2 × loading dye. After which, the gel was stained with ethidium bromide for 5 min, and DNA bonds were visualized under the Azure 200 Gel Imaging Workstation. After checking for single bond amplifications of fungal endophyte isolates, PCR products (50 µl) were prepared for sequencing through Noveaulab Asia Corporation.
Bioinformatics and statistical analyses
Chromatograms were processed using BioEdit software. The universal primers and paired-end reads were first removed. Forward and reverse sequences were aligned and a consensus sequence was generated. The resulting DNA sequences of the fungal endophyte isolates were analyzed using BLAST. Nucleotide sequences of the fungal endophytes were identified by comparison to those in the GenBank database. Maximum score and percent identity are the basis of determining the top three blast hits for each fungal endophyte isolate. Evolutionary analyses were conducted using MEGA11. The relationship among the isolates was inferred using the neighbor-joining method. A consensus tree was generated from 1000 replicates, with bootstrapping performed from the taxa analyzed.
All data were statistically analysed using analysis of variance (ANOVA) and the computed antagonistic activity of Cardaba fungal endophytes were compared using the Tukey Honestly Significant Difference (HSD) test at 0.05 level of significance using IBM SPSS statistical software.
Results
Fungal endophytes from healthy Cardaba banana
A total of 15 fungal endophytes isolates were obtained from the leaves, pseudostem, and roots of Cardaba banana. There were 11 fungal endophytes isolated from Cardaba banana leaves, three isolates from the pseudostem and one from the roots (Fig. 3). In the dual culture test, 10 out of the 15 fungal endophyte isolates grew faster than F. odoratissimum, while five isolates were slow-growing (Fig. 4). Four of the 10 fungal endophyte isolates occupied half of the plate and two isolates overgrew the pathogen by at least two-thirds. Four isolates USMJMTBL1, USMJMTBL11, USMJMTBP3, and USMJMTBR1 completely overgrown the pathogen at 7 days after incubation (DAI).
In terms of growth inhibition, all fungal endophyte isolates displayed antagonistic activity against F. odoratissimum, albeit at varying degrees of antagonism (Table 1). Within 14 DAI, the growth of F. odoratissimum was suppressed by all fungal endophyte isolates, except for USMJMTBL1. Moderate inhibition, exceeding 50%, was observed in three isolates, while 7 fungal endophyte isolates exhibited high inhibition percentages ranging from 61 to 75% against F. odoratissimum. Notably, the growth of F. odoratissimum was greatly reduced by the isolates USMJMTBR1 (96.56%), USMJMTBL10 (93.33%), and USMJMTBL11 (87.77%). However, isolates USMJMTBL1 and USMJMTBL2 exhibited low inhibition against the pathogen with only 46.67%. At 7 DAI, USMJMTBL1 exhibited faster growth compared to F. odoratissimum, but by 14 DAI, regrowth of F. odoratissimum was observed, indicating that USMJMTBL1 was unable to effectively inhibit the growth of the pathogen.
Morpho-cultural identity of the fungal endophyte isolates
The ten fungal endophyte isolates were characterized through combined morphological and cultural traits. Most of the fungal colonies had a circular shape while others had semi-circular or irregular shape (Table 2). More than 50% of the fungal endophyte isolates had cottony and/or fluffy to powdery or granular texture, while others had a web-like appearance. Majority of the isolates had white to pale white mycelium. Some isolates exhibited scattered black spots and pale white patches at the edge when viewed in reverse, while one isolate had dark grey mycelium. The average growth diameter of the fungal colonies ranged from 70 to 90 mm at 7 DAI on the PDA plate.
On morphological characteristics shown in (Table 2 and Fig. 5), the shape of conidia varied from spherical to cylindrical to elliptical, and from micro to macroconidia. Most fungal hyphae were hyaline or clear/non-pigmented to pale and dark brown. The majority had septa and varied from branched, highly branched to highly coiled hyphae. Based on the cultural and morphological characteristics, isolates were identified as Blakeslea, Colletotrichum, Fusarium, Gymnoascus, Macrophomina, Nigrospora, Pseudopestalotiopsis, Rigidoporus, and Xylaria but were subjected to molecular confirmation.
Molecular identity of the fungal endophyte isolates
Optimization of the PCR amplification of the fungal endophytes revealed successful amplification of all PCR products of the pathogen using annealing temperatures (VeriFlex) of 52 °C for USMJMTBL5, 54 °C for USMJMTBP1, USMJMTBP3, and USMJMTBR1, 56 °C for USMJMTBL3, USMJMTBL4, and USMJMTBL6 and 58 °C for USMJMTBL1, USMJMTBL10, and USMJMTBL11. Table 3 shows the closest similar organisms with significant BLAST hits to the fungal endophyte isolates, at 86–99% similarity, and their corresponding biological roles.
Comparison of the antagonistic activity of the fungal endophytes against F. odoratissimum
Among the 10 fungal endophyte isolates (Table 4), B. trispora (USMJMTBL1) had the least antagonistic activity but comparable to X. badia (USMJMTBL4). The isolates X. feejeensis (USMJMTBL10), G. reesii (USMJMTBL11), and M. phaseolina (USMJMTBR1) had the highest antagonistic activity and were significantly different from B. trispora (USMJMTBL1), P. theae (USMJMTBL3), X. badia (USMJMTBL4), N. hainanensis (USMJMTBL5), C. gloeosporioides (USMJMTBL6), F. subglutinans (USMJMTBP1), and R. vinctus (USMJMTBP3).
Discussion
Majority of the fungal endophytes were isolated from the leaves of Cardaba while a small number was obtained from the pseudostem and roots. The variation in the abundance of fungal endophytes among the different plant tissues could be influenced by environmental conditions which may affect their functional activity (Horner-Devine et al. 2007). The PCR amplification using the ITS1 and ITS4 primer pair resulted in ~ 650 base pair (bp) product from all fungal endophytes isolated, which falls within the typical size range of rDNA ITS amplicon size for fungal isolates (Catambacan and Cumagun 2021). Some of the fungal endophytes isolated in this study demonstrated fast growth compared to the growth of the F. odoratissimum pathogen, suggesting that they may have competitive advantage when coexisting with other fungi in a plant host. This often leads to a high isolation frequency for fast-growing endophytes in various habitats (Huang 2020). One such isolate, USMJMTBL1 (B. trispora) exhibited rapid growth but failed to inhibit F. odoratissimum at 14 DAI. Its relationship with the pathogen remains unclear and warrants further investigation.
Out of the 15 fungal endophytes examined, 10 isolates exhibited notable antagonistic activity against F. odoratissimum. These isolates demonstrated the ability to overgrow the pathogen and displayed varying degrees of antagonism, ranging from moderate to very high. The variability in the degree of antagonism of the 10 fungal endophyte isolates against F. odoratissimum could be attributed to the different mechanisms of antagonistic activity they employ, such as competition, antibiosis, and parasitism (Nuraini et al. 2017). Competition with the pathogen was observed in endophytic fungal isolates including USMJMTBL4 (X. badia), USMJMTBL6 (C. gloeosporioides), USMJMTBP1 (F. subglutinans), and USMJMTBR1 (M. phaseolina). These isolates demonstrated dominance over the pathogen by occupying a larger surface of the culture medium. USMJMTBR1 (M. phaseolina) displayed the highest level of dominance over the pathogen, as evidenced by the growth inhibition and Bell’s ratings. This suggests that the nutritional needs of F. odoratissimum may have been disrupted, leading to a decline in the germination percentage of the fungal spores (Berlian et al. 2013). Endophytes employing the competition mechanism act by colonizing and foraging nutrients, as well as occupying the space that pathogens would typically utilize for their activities (Rodriguez et al. 2009).
The mechanism of antibiosis was observed in the case of USMJMTBL3 (P. theae). Notably, a narrow demarcation line was observed between this isolate and F. odoratissimum. This inhibition could be attributed to the production of volatile organic compounds or antibiotic substances by P. theae, which hindered the further growth of the pathogen (Mahendran et al. 2021). Fungal endophytes are known to alleviate the consequences and severity of pathogenic infections by producing various effective secondary metabolites (Gao et al. 2010). In addition, Kurnia et al. (2014) explained that active compounds produced by endophytic microbes cause the hyphae of fungal pathogens to undergo malformations. Endophytic M. phaseolina was reported to produce secondary metabolites and volatile compounds (Singh et al. 2022) and in this study, this isolate exhibited a very high degree of antagonism against F. odoratissimum.
Two species of Xylaria in this study have varying degrees of antagonism. Xylaria species are known to produce a diverse array of secondary metabolites including volatile and non-volatile compounds, and aromatic compounds. These metabolites have demonstrated potential activity as herbicides, fungicides, and insecticides, while others possess antibacterial, antimalarial, and antifungal properties (Macías-Rubalcava and Sánchez-Fernández 2016.) The X. feejeensis isolate in this study displayed a growth inhibition of 93.33%, indicating a very high degree of antagonism against F. odoratissimum. The crude extract of X. feejeensis isolated from a mangrove tree was reported to inhibit F. oxysporum, the causative agent of Fusarium wilt and Alternaria solani which causes early blight in tomato (Brooks et al. 2022). The X. badia isolate in this study showed a growth inhibition of 53.33%, indicating a moderate degree of antagonism against the pathogen. Oppong et al. (2010) reported the isolation of secondary metabolites benzoquinone and naphthol glucoside from X. badia.
The G. reessii isolate in this study completely overgrew the pathogen and displayed a very high degree of antagonism. Liu et al. (2017) reported that the G. reessii isolated from the rhizosphere of tomato plants produced metabolite known as gymnoascole acetate, which significantly reduced root-knot nematode population. Furthermore, an endophytic N. hainanensis isolate from Carbada banana demonstrated a high degree of antagonism against the banana pathogen. It was reported that the endophytic fungus Nigrospora sp. isolated from the roots of Moringa oleifera Lam produces antifungal secondary metabolites such as griseofulvin which exhibited clear growth inhibition against 8 plants’ pathogenic fungi (Zhao et al. 2012).
The C. gloeosporioides and R. vinctus isolates from Cardaba banana in this study demonstrated a growth inhibition of 63.89% and displayed a high degree of antagonism against F. odoratissimum. Previous research has indicated that C. gloeosporioides has antagonistic effect against tea pathogen C. camelliae in vitro (Rabha et al. 2014). Additionally, C. gloeosporioides has been found to produce compounds against various bacterial, fungal, and parasitic protozoan pathogens (Denise et al. 2008). In the case of endophytic R. vinctus, it has shown activity against Cladosporium oxysporum (Renuka and Ramanujam 2016).
This study also isolated P. theae and F. subglutinans from Cardaba banana, both of which exhibited a growth inhibition of 61.67% and displayed a high degree of antagonism against F. odoratissimum. In the study of Yu et al. (2020), endophytic fungus P. theae produced secondary metabolites which showed moderate antibacterial activity against drug-resistant Acinetobacter baumannii. The endophytic F. subglutinans with a high degree of antagonism against F. odoratissimum in this study showed no records of biological control agents, but can be subjected to further investigation for prospecting of bioactive compounds. Despite the lowest degree of antagonism observed in B. trispora in this study, it is widely used for large-scale carotenoid production (Luo et al. 2020).
The mechanism of parasitism was observed in several fungal endophyte isolates, namely USMJMTBL1 (B. trispora), USMJMTBL5 (N. hainanensis), USMJMTBL10 (X. feejeensis), USMJMTBL11 (G. reessii), and USMJMTBP3 (R. vinctus), as indicated by the visual overlapping of these endophytes with the surface of the pathogen. Fungal endophytes can develop hooks around the hyphae of fungal pathogens prior to penetration, and/or some cases, they can directly enter the fungal pathogens (Dolatabadi et al. 2012).
Conclusions
Only the in vitro assay was conducted in this study with the aim is to screen and evaluate potential endophytes against the F. odoratissimum. Our findings suggest that Cardaba fungal endophytes had the potential to be utilized as a biocontrol agent against F. odoratissimum (Foc TR4). The fungal endophytes isolated from Cardaba banana have potential mechanisms of competition, antibiosis, and parasitism. Further investigation into the specific control mechanisms of these isolates would allow for a deep understanding of their potential as a biocontrol agent. Future research will focus on the in planta testing, validation in greenhouse and field trials, as well as the development of formulations and application protocols to optimize the utilization of the biocontrol agent in an integrated management approach for Foc TR4-infected bananas. The development of sustainable and environmentally-friendly biocontrol agents based on these findings could help address the economic challenges faced in banana production caused by this pathogen.
Availability of data and materials
Not applicable.
Abbreviations
- BLAST:
-
Basic Local Alignment Search Tool
- DAI:
-
Days after incubation
- HSD:
-
Honestly Significant Difference
- MEA:
-
Malt Extract Agar
- MEGA:
-
Molecular Evolutionary Genetics Analysis
- NCBI:
-
National Center for Biotechnology Information
- PDA:
-
Potato Dextrose Agar
References
Ahmad F, Martawi NM, Poerba YS, de Jong H, Schouten H, Kema GHJ (2020) Genetic mapping of Panama wilt resistance in a wild banana Musa acuminata ssp. malaccensis accession. Theor Appl Genet 133:3409–3418. https://doi.org/10.1007/s00122-020-03677-y
Arnold EA (2007) Understanding the diversity of foliar endophytic fungi: progress, challenges, and frontiers. Fungal Biol Rev 21:51–66. https://doi.org/10.1016/j.fbr.2007.05.003
Barnett HL, Hunter BB (1998) Illustrated genera of imperfect fungi, 4th edn. APS Press, St. Paul
Bell DK, Wells HD, Markham CR (1982) In vitro antagonism of Trichoderma spp. against six fungal plant pathogens. Phytopathology 72:379–382. https://doi.org/10.1094/Phyto-72-379
Berlian I, Setyawan B, Hadi H (2013) Antagonist mechanism of Trichoderma spp. against some soil contagious pathogens. Warta Perkaretan 32(2):74–82
Brooks S, Klomchit A, Chimthai S, Jaidee W, Bastian AC (2022) Xylaria feejeensis, SRNE2BP a fungal endophyte with biocontrol properties to control early blight and Fusarium wilt disease in tomato and plant growth promotion activity. Curr Microbiol 79(4):108. https://doi.org/10.1007/s00284-022-02803-x
Catambacan DG, Cumagun CJR (2021) Weed-associated fungal endophytes as biocontrol agents of Fusarium oxysporum f. sp. cubense TR4 in Cavendish banana. J Fungus 7(3):224. https://doi.org/10.3390/jof7030224
Chen A, Sun J, Matthews A, Armas-Egas L, Chen N, Hamill S, Mintoff S, Tran-Nguyen LTT, Batley J, Aitken EAB (2019) Assessing variations in host resistance to Fusarium oxysporum f. sp. cubense Race 4 in Musa species, with a focus on the subtropical race 4. Front Microbiol. https://doi.org/10.3389/fmicb.2019.01062
Denise O, Guimaraes DO, Borges WS, Kawano CY, Ribeiro PH, Goldman GH, Nomizo A, Thiemann OH, Oliva G, Lopes NP, Pupo MT (2008) Biological activities from extracts of endophytic fungi isolated from Viguiera arenaria and Tithonia diversifolia. FEMS Immunol Med Microbiol 52:134–144. https://doi.org/10.1111/j.1574-695X.2007.00354.x
Department of Agriculture (2019) Philippine banana industry roadmap 2019–2022. https://www.da.gov.ph/wp-content/uploads/2019/06/Philippine-Banana-Industry-Roadmap-2019-2022.pdf. Accessed 25 Apr 2022
Dita M, Barquero M, Heck D, Mizubuti ESG, Staver CP (2018) Fusarium wilt of banana: current knowledge on epidemiology and research needs toward sustainable disease management. Front Plant Sci. https://doi.org/10.3389/fpls.2018.01468
Dolatabadi HK, Goltapeh EM, Mohammadi N, Rabiey M, Rohani N, Varma A (2012) Biocontrol potential of root endophytic fungi and Trichoderma species against Panama wilt of lentil under in vitro and greenhouse conditions. J Agric Sci Technol 14(2):407–420
FAO (2021) Banana market review: preliminary results 2020. https://www.fao.org/3/cb5150en/cb5150en.pdf. Accessed 24 Apr 2022
Fokkema NJ (1973) The role of saprophytic fungi in antagonism against Drechslera sorokiniana (Helminthosporium sativum) on agar plates and on rye leaves with pollen. Physiol Plant Pathol 3:195–205. https://doi.org/10.1016/0048-4059(73)90082-9
Fravel D, Olivain C, Alabouvette C (2003) Fusarium oxysporum and its biocontrol. New Phytol 157(3):493–502. https://doi.org/10.1046/j.1469-8137.2003.00700.x
Gao FK, Dai CC, Liu XZ (2010) Mechanisms of fungal endophytes in plant protection against pathogens. Afr J Microbiol Res 4:1346–1351. https://doi.org/10.5897/AJMR.9000480
Horner-Devine MC, Silver JM, Leibold MA, Bohannan BJM, Colwell RK, Fuhrman JA, Green JL, Kuske CR, Martiny JBH, Muyzer G, Ovreas L, Reysenbach AL, Smith VH (2007) A comparison of taxon co-occurrence patterns for macro-and microorganisms. Ecology 88(6):1345–1353. https://doi.org/10.1890/06-0286
Huang YL (2020) Effect of host, environment and fungal growth on fungal leaf endophyte communities in Taiwan. J Fungi 6(4):244. https://doi.org/10.3390/jof6040244
Khan N, Hidalgo PM, Ice TA, Maymon M, Humm EA, Nejat N, Sanders ER, Kaplan D, Hirsch AM (2018) Antifungal activity of Bacillus species against Fusarium and analysis of the potential mechanisms used in biocontrol. Front Microbiol 9:2363. https://doi.org/10.3389/fmicb.2018.02363
Kurnia AT, Pinem MI, Oemry S (2014) Use of endophytic fungus to control Fusarium oxysporum f. sp. capsici and Alternaria sola in vitro. Agroekoteknologi 2(4):1596–1606
Leslie JF, Summerell BA (2006) The Fusarium laboratory manual. Wiley, Ames. https://doi.org/10.1002/9780470278376
Li WM, Dita M, Wu W, Hu GB, Xie JH, Ge XJ (2014) Resistance sources to Fusarium oxysporum f. sp. cubense tropical race 4 in banana wild relatives. Plant Pathol 64:1061–1067. https://doi.org/10.1111/ppa.12340
Liu T, Meyer SLF, Chitwood DJ, Chauhan KR, Dong D, Zhang TT, Li J, Liu WC (2017) New nematotoxic indoloditerpenoid produced by Gymnoascus reessii za-130. J Agric Food Chem 65(15):3127–3132. https://doi.org/10.1021/acs.jafc.6b04353
Luo W, Xue C, Zhao Y, Zhang H, Rao Z, Yu X (2020) Blakeslea trispora photoreceptors: identification and functional analysis. Appl Environ Microbiol 86(8):e02962-e3019. https://doi.org/10.1128/aem.02962-19
Macías-Rubalcava ML, Sánchez-Fernández RE (2016) Secondary metabolites of endophytic Xylaria species with potential applications in medicine and agriculture. World J Microbiol Biotechnol. https://doi.org/10.1007/s11274-016-2174-5
Mahendran TR, Thottathil GP, Surendran A, Nagao H, Sudesh K (2021) Biocontrol potential of Aspergillus terreus, endophytic fungus against Rigidoporus microporus and Corynespora cassiicola, pathogens of rubber tree. Arch Phytopathol Pflanzenschutz 54(15–16):1014–1032. https://doi.org/10.1080/03235408.2021.1884952
Mishra Y, Sharma L, Dhiman M, Sharma MM (2021) Endophytic fungal diversity of selected medicinal plants and their bio-potential applications. Fungi Bio-Prospects Sustain Agri Environ Nano-Technol 1:227–283. https://doi.org/10.1016/b978-0-12-821394-0.00010-x
Molina AB, Sinohin VO, Fabregar EG, Ramillete EB, Loayan MM, Chao CP (2016) Field resistance of Cavendish somaclonal variants and local banana cultivars to tropical race 4 of Panama wilt in the Philippines. Acta Hortic 1114:227–230. https://doi.org/10.17660/ActaHortic.2016.1114.31
Molina AB, Fabregar EG, Sinohin V, Herradora L, Fourie G, Viljoen A (2008) Tropical race 4 of Fusarium oxysporum f. sp. cubense causing new Panama wilt epidemics in Cavendish varieties in the Philippines. https://www.apsnet.org/meetings/Documents/2008_Meeting_Abstracts/a08ma559.htm. Accessed 24 Apr 2022
Nakkeeran S, Rajamanickam S, Saravanan R, Vanthana M, Soorianathasundaram K (2021) Bacterial endophytome-mediated resistance in banana for the management of Panama wilt. 3 Biotech 11:267. https://doi.org/10.1007/s13205-021-02833-5
Nuraini FR, Setyaningsih R, Susilowati A (2017) Screening and characterization of endophytic fungi as antagonistic agents toward Fusarium oxysporum on eggplant (Solanum melongena). Biodiversitas 18(4):1377–1384. https://doi.org/10.13057/biodiv/d180413
Olaoye OA, Ade-Omowaye BIO (2011) Composite flours and breads: Potential of local crops in developing countries. Flour Breads Fortif Health Dis Prev. https://doi.org/10.1016/b978-0-12-380886-8.10017-0
Oppong EK, Edwards RL, Maitland DJ, Hanson R (2010) Metabolites from static cultures of the fungus Xylaria badia. Int J Appl Chem 6(3):387–394
Perez-Vicente L, Dita MA, Martinez-de la Parte E (2014) Technical manual prevention and diagnostic of Fusarium wilt (Panama wilt) of banana caused by Fusarium oxysporum f. sp. cubense tropical race 4 (TR4). Rome, Italy
Pujade-Renaud V, Déon M, Gazis R, Ribeiro S, Dessailly F, Granet F, Chaverri P (2019) Endophytes from wild rubber trees as antagonists of the pathogen Corynespora cassiicola. Phytopathology 109(11):1888–1899. https://doi.org/10.1094/PHYTO-03-19-0093-R
Rabha AJ, Naglot A, Sharma GD, Gogoi HK, Veer V (2014) In vitro evaluation of antagonism of endophytic Colletotrichum gloeosporioides against potent fungal pathogens of Camellia sinensis. Indian J Microbiol 54(3):302–309. https://doi.org/10.1007/s12088-014-0458-8
Rahman MA, Begum MF, Alam MF (2009) Screening of Trichoderma isolates as a biological control agent against Ceratocystis paradoxa causing pineapple disease of sugarcane. Mycobiology 37(4):277–285. https://doi.org/10.4489/myco.2009.37.4.277
Renuka S, Ramanujam B (2016) Fungal endophytes from Maize (Zea mays L.): isolation, identification and screening against maize stem borer, Chilo partellus (Swinhoe). J Pure Appl Microbiol 10(1):523–528
Rodriguez RJ, White JF Jr, Arnold AE, Redman RS (2009) Fungal endophytes: diversity and functional roles. New Phytol 182(2):314–330. https://doi.org/10.1111/j.1469-8137.2009.02773.x
Rudgers JA, Holah J, Orr SP, Clay K (2007) Forest succession suppressed by an introduced plant-fungal symbiosis. Ecology 88(1):18–25. https://doi.org/10.1890/0012-9658(2007)88[18:FSSBAI]2.0.CO;2
Singh G, Kumar A, Verma MK (2022) Secondary metabolites produced by Macrophomina phaseolina, a fungal root endophyte of Brugmansia aurea, using classical and epigenetic manipulation approach. Folia Microbiol (Praha) 67:793–799. https://doi.org/10.1007/s12223-022-00976-3
Solpot TC, Pangga IB, Baconguis RD, Cumagun CJR (2016) Occurrence of Fusarium oxysporum f. sp. cubense tropical race 4 and other genotypes in Banana in South-Central Mindanao, Philippines. Philipp Agric Sci 99(4):370–378
Soytong K (1988) Identification of species of Chaetomium in the Philippines and screening for their biocontrol properties against seed borne fungi of rice. Dissertation, University of the Philippines Los Baños, College, Laguna, Philippines
Thambugala KM, Daranagama DA, Phillips AJL, Kannangara SD, Promputtha I (2020) Fungi vs. fungi in biocontrol: an overview of fungal antagonists applied against fungal plant pathogens. Front Cell Infect Microbiol. https://doi.org/10.3389/fcimb.2020.604923
Thangavelu R, Mostert D, Gopi M, Devi PG, Padmanaban B, Molina AB, Viljoen A (2019) First detection of Fusarium oxysporum f. sp. cubense tropical race 4 (TR4) on Cavendish banana in India. Eur J Plant Pathol 154:777–786. https://doi.org/10.1007/s10658-019-01701-6
White TJ, Bruns T, Lee S, Taylor J (1990) Amplification and direct sequencing of fungal ribosomal RNA genes for phylogenetics. In: Innis MA, Gelfand DH, Sninsky JJ, White TJ (eds) PCR protocols: a guide to methods and applications. Academic Press Inc, San Diego, pp 315–322
Xue C, Ryan Penton C, Shen Z, Zhang R, Huang Q, Li R, Ruan Y, Shen Q (2015) Manipulating the banana rhizosphere microbiome for biological control of Panama disease. Sci Rep 5:11124. https://doi.org/10.1038/srep11124
Yu X, Müller WEG, Meier D, Kalscheuer R, Guo Z, Zou K, Umeokoli BO, Liu Z, Proksch P (2020) Polyketide derivatives from mangrove derived endophytic fungus Pseudopestalotiopsis theae. Mar Drugs 18(2):129. https://doi.org/10.3390/md18020129
Zhao JH, Zhang YL, Wang LW, Wang JY, Zhang CL (2012) Bioactive secondary metabolites from Nigrospora sp. LLGLM003, an endophytic fungus of the medicinal plant Moringa oleifera Lam. World J Microbiol Biotechnol 28:2107–2112. https://doi.org/10.1007/s11274-012-1015-4
Zuo CW, Deng GM, Li B, Huo HQ, Li CY, Hu CH, Kuang R, Yang QS, Dong T, Sheng O, Yi G (2018) Germplasm screening of Musa spp. for resistance to Fusarium oxysporum f. sp cubense tropical race 4 (Foc TR4). Eur J Plant Pathol 151:723–734. https://doi.org/10.1007/s10658-017-1406-3
Acknowledgements
This study was financially supported by the Department of Agriculture-Biotechnology scholarship to JMFT.
Funding
Department of Agriculture-Biotechnology (PH).
Author information
Authors and Affiliations
Contributions
JMFT performed the experiment, analyzed the data and wrote the manuscript with MTNC. BTB and MTNC designed and supervised the experiment. BLPB and MENT collaborated in the editing and review of the manuscript and analysis of the data. All authors read and approved the final manuscript.
Corresponding authors
Ethics declarations
Ethics approval and consent to participate
Not applicable.
Consent for publication
We agree to publish this paper in the EJBPC.
Competing interests
The authors declare no competing interests.
Additional information
Publisher's Note
Springer Nature remains neutral with regard to jurisdictional claims in published maps and institutional affiliations.
Rights and permissions
Open Access This article is licensed under a Creative Commons Attribution 4.0 International License, which permits use, sharing, adaptation, distribution and reproduction in any medium or format, as long as you give appropriate credit to the original author(s) and the source, provide a link to the Creative Commons licence, and indicate if changes were made. The images or other third party material in this article are included in the article's Creative Commons licence, unless indicated otherwise in a credit line to the material. If material is not included in the article's Creative Commons licence and your intended use is not permitted by statutory regulation or exceeds the permitted use, you will need to obtain permission directly from the copyright holder. To view a copy of this licence, visit http://creativecommons.org/licenses/by/4.0/.
About this article
Cite this article
Taping, J.M.F., Borja, B.T., Bretaña, B.L.P. et al. Fungal endophytes as potential biocontrol agent of Panama disease of banana. Egypt J Biol Pest Control 33, 84 (2023). https://doi.org/10.1186/s41938-023-00727-7
Received:
Accepted:
Published:
DOI: https://doi.org/10.1186/s41938-023-00727-7